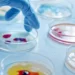
Θλιβερή πρωτιά της Ελλάδας στην ΕΕ σε θανάτους από λοιμώξεις – Το νέο σχέδιο του υπουργείου Υγείας για τα αντιβιοτικά

Δύο ημέρες ύστερα από ιρανικά πλήγματα στο έδαφός του, το Πακιστάν ανακοίνωσε σήμερα ότι απάνρτησε με «πλήγματα εναντίον κρησφύγετων τρομοκρατών» – Ποιοί είναι οι αυτονομιστές Βελούχοι που στοχοθετήθηκαν από το Ισλαμαμπάντ
Δύο ημέρες ύστερα από ιρανικά πλήγματα στο έδαφός του, το Πακιστάν ανακοίνωσε σήμερα ότι διεξήγαγε τη νύχτα “πλήγματα εναντίον κρησφύγετων τρομοκρατών” στο Ιράν από τα οποία έχασαν τη ζωή τους 9 άνθρωποι, εκ των οποίων 4 παιδιά και 3 γυναίκες, σύμφωνα με ιρανικά κρατικά μέσα ενημέρωσης.
#Engrenage–Frappes du Pakistan en Iran, base US attaquée en Syrie, frappes américaines au Yémen: le Moyen Orient s’embrase
L’inexorable spirale menant vers un conflit mondial s’accélère alors que se dessine l’ouverture d’un nouveau front au Balochistan:
au lendemain d’une… pic.twitter.com/95SYAKUTFV
— Frédéric Aigouy (@frederic_RTfr) January 18, 2024
“Σήμερα το πρωί το Πακιστάν διεξήγαγε σειρά πληγμάτων ακριβείας, υψηλού συντονισμού και στοχευμένων συγκεκριμένα, εναντίον κρησφύγετων τρομοκρατών στην επαρχία Σιστάν-Μπαλουτσιστάν” στο νοτιοανατολικό Ιράν, αναφέρει σε ανακοίνωση που εξέδωσε το υπουργείο Εξωτερικών του Πακιστάν.
“Το μέτρο (…) ελήφθη βάσει αξιόπιστων πληροφοριών για επικείμενες τρομοκρατικές δραστηριότητες σε μεγάλη κλίμακα”, διευκρίνισε το πακιστανικό υπουργείο, προσθέτοντας ότι “ένας αριθμός τρομοκρατών” σκοτώθηκε.
🇵🇰🇮🇷⚡ Pakistan Retaliates With Strikes Against Iran
Airstrikes allegedly targeted the Balochistan Liberation Army in Sistan-Balochistan. Multiple targets were hit, according to reports. pic.twitter.com/XXiEUdvItE
— War Watch (@WarWatchs) January 18, 2024
“Το Πακιστάν σέβεται απολύτως την κυριαρχία και την εδαφική ακεραιότητα της Ισλαμικής Δημοκρατίας του Ιράν”, διαβεβαίωσε επίσης το πακιστανικό υπουργείο Εξωτερικών, προσθέτοντας ότι “ο μόνος στόχος της σημερινής ενέργειας ήταν να εργαστούμε για την ασφάλεια του Πακιστάν και προς το εθνικό μας συμφέρον, που είναι καίριας σημασίας και δεν μπορούν να διακυβευτούν”.
Τουλάχιστον 9 άνθρωποι έχασαν τη ζωή τους, εκ των οποίων 4 παιδιά και 3 γυναίκες “όλοι μη ιρανικής υπηκοότητας” σε μεθοριακά χωριά από τα πλήγματα αυτά, μετέδωσαν τα κρατικά μέσα ενημέρωσης του Ιράν, επικαλούμενα τον αντικυβερνήτη της επαρχίας Σιστάν-Μπαλουτσιστάν Αλιρεζά Μαρχαματί.
#Pakistan launched precision guided rockets at city of #Saravan in Southern Iran in response to the recent attacks of #IRGC to AlQaeda affiliated Jaish ul-Adl terrorist group in Balochistan province of Pakistan!
A number of houses in the city of Saravan and its surrounding areas… pic.twitter.com/Yp4ulyEfTz— Mohammad Ali Taheri Movement (@Taheri_Movement) January 18, 2024
“Οι δυνάμεις μας διεξήγαγαν πλήγματα με στόχο μαχητές Βελούχους εντός του Ιράν”, διευκρίνισε ο αξιωματούχος αυτός από το Ισλαμαμπάντ.
“Οι μαχητές που μπήκαν στο στόχαστρο ανήκουν στο BLF”, πρόσθεσε, αναφερόμενος στο Απελευθερωτικό Μέτωπο των Βελούχων, το οποίο επιδιώκει την ανεξαρτησία της δυτικής πακιστανικής επαρχίας Μπαλουτσιστάν (Βελουχιστάν).
Mainly Saravan city near the border was targeted by Pakistani army with multiple explosion.
Pakistani medias says Pakistan has asked for public excuses from Iran which refused it. pic.twitter.com/sOA1ezIa2z
— Eternal Glory (@EternalGlory0) January 18, 2024
Ο εκπρόσωπος του υπουργείου Εξωτερικών του Ιράν Νασέρ Καναανί δήλωσε ότι το Ιράν καταδικάζει έντονα τα πλήγματα, προσθέτοντας ότι ο επιτετραμμένος του Πακιστάν στην Τεχεράνη εκλήθη να δώσει εξηγήσεις.
Η Τεχεράνη είχε ανακοινώσει το βράδυ της Τρίτης πως διεξήγαγε πλήγματα εναντίον θέσεων “τρομοκρατών” στο έδαφος του Πακιστάν και το Ισλαμαμπάντ είχε αντιδράσει χθες Τετάρτη, χαρακτηρίζοντας “εντελώς απαράδεκτη” και αδικαιολόγητη την επίθεση αυτή, που είχε αποτέλεσμα να χάσουν τη ζωή τους δυο παιδιά.
Το Πακιστάν, στο οποίο αναμένεται να διεξαχθούν γενικές εκλογές στις 8 Φεβρουαρίου, ανακάλεσε επίσης τον πρεσβευτή του από την Τεχεράνη και αποφάσισε να εμποδίσει την επιστροφή του Ιρανού πρεσβευτή στο Ισλαμαμπάντ, ο οποίος βρίσκεται το τρέχον διάστημα στη χώρα του.
Σύμφωνα με το ιρανικό πρακτορείο ειδήσεων Mehr, η ιρανική επίθεση “με πύραυλο και drone” είχε στόχο το γενικό επιτελείο στο Πακιστάν της τζιχαντιστικής οργάνωσης Τζάις αλ Αντλ (Στρατός της δικαιοσύνης στα αραβικά) σε απάντηση σε “επίθεση κατά της ασφάλειας” του Ιράν.
Τον Δεκέμβριο η Τζάις αλ Αντλ είχε αναλάβει την ευθύνη για επίθεση σε αστυνομικό τμήμα στο Ρασκ, στο Σιστάν-Μπαλουτσιστάν, στην οποία σκοτώθηκαν 11 Ιρανοί αστυνομικοί.
Ο ιρανός υπουργός Εξωτερικών Χοσεΐν Αμίρ-Αμπντολαχιάν δήλωσε εξάλλου χθες ότι “η Τζάις αλ Αντλ είναι τρομοκρατική οργάνωση που δρα κατά της κοινής ασφάλειας των δύο χωρών”.
Το Ιράν και το Πακιστάν αλληλοκατηγορούνται συχνά ότι επιτρέπουν σε ανταρτικές οργανώσεις να επιχειρούν από το έδαφος των χωρών τους για να εξαπολύουν επιθέσεις, αλλά σπάνια υπάρχει εμπλοκή των ενόπλων δυνάμεών τους.
Τα πλήγματα αυτά γίνονται την ώρα που η Μέση Ανατολή συγκλονίζεται από τον πόλεμο ανάμεσα στο παλαιστινιακό ισλαμιστικό κίνημα Χαμάς και το Ισραήλ στην Λωρίδα της Γάζας και τις επιθέσεις των ανταρτών Χούτι της Υεμένης, οι οποίοι υποστηρίζονται από το Ιράν, κατά εμπορικών πλοίων στην Ερυθρά Θάλασσα.
Ποιοί είναι οι αυτονομιστές που στοχοθετήθηκαν από τα πλήγματα του Πακιστάν στο Ιράν;
Ακολουθούν μερικές πληροφορίες για την οργάνωση που στοχοθετήθηκε από το Πακιστάν και την ταραγμένη επαρχία μεθοριακή επαρχία του Μπαλουτσιστάν (Βελουχιστάν) που βρίσκεται στην καρδιά των εντάσεων.
Ποιά οργάνωση στοχοθέτησε το Πακιστάν στο Ιράν
Το Απελευθερωτικό Μέτωπο των Βελούχων (BLF), για το οποίο αξιωματούχος των υπηρεσιών πληροφοριών είπε πως ήταν ο στόχος των πακιστανικών πληγμάτων στο Ιράν, επιδιώκει την ανεξαρτησία της δυτικής πακιστανικής επαρχίας του Μπαλουτσιστάν (Βελουχιστάν).
Οι μαχητές της εθνότητας των Βελούχων (Μπαλούτς) πολεμούν εναντίον της κυβέρνησης εδώ και δεκαετίες για τη δημιουργία ενός χωριστού κράτους, υποστηρίζοντας πως η κεντρική κυβέρνηση εκμεταλλεύεται άδικα τους πλούσιους φυσικούς πόρους αερίου και μεταλλευμάτων της επαρχίας του Μπαλουτσιστάν, η οποία συνορεύει με το Αφγανιστάν και το Ιράν.
Το BLF είναι μεταξύ των εξεγερμένων που συχνά στοχοθετούν εγκαταστάσεις αερίου, υποδομές και θέσεις ασφαλείας εκεί, όμως έχουν αρχίσει να εξαπολύουν επιθέσεις και σε άλλα μέρη του Πακιστάν.
Επιτίθενται επίσης σε κινεζικά εργοτάξια και σκοτώνουν ευκαιριακά Κινέζους εργάτες, παρά τις διαβεβαιώσεις από το Πακιστάν ότι κάνει ό,τι μπορεί για να προστατεύει τα κινεζικά εργοτάξια.
Ποιά είναι η σημασία του Μπαλουτσιστάν (Βελουχιστάν);
Η εκταταμένη αυτή επαρχία, όπου ζουν περίπου 15 εκατομμύρια άνθρωποι, είναι ως επί το πλείστον ένα άνυδρο, ερημικό και ορεινό έδαφος που έχει ανεκμετάλλευτο ορυκτό πλούτο.
Είναι η μεγαλύτερη σε μέγεθος επαρχία του Πακιστάν, αλλά με το μικρότερο πληθυσμό. Συνορεύει με την ιρανική επαρχία Σιστάν-Μπαλουτσιστάν, όπου πραγματοποίησε τα πλήγματα το Πακιστάν.
Εκατοντάδες Βελούχοι διαδηλωτές, πολλοί από τους οποίους γυναίκες, έχουν πραγματοποιήσει διαμαρτυρίες τις τελευταίες εβδομάδες στο Ισλαμαμπάντ, την πρωτεύουσα του Πακιστάν, διατυπώνοντας κατηγορίες για τη μεταχείριση της οποίας τυγχάνουν οι κάτοικοι της επαρχίας – μεταξύ άλλων εξαναγκαστικές εξαφανίσεις και εξωδικαστικές εκτελέσεις.
Το Μπαλουτσιστάν (Βελουχιστάν) είναι μια σημαντική τοποθεσία για τον τεράστιο και πολλών δισεκατομμυρίων Οικονομικό Διάδρομο Κίνας Πακιστάν (CPEC), ο οποίος αποτελεί μέρος της πρωτοβουλίας Μία Ζώνη Ένας Δρόμος του προέδρου Σι Τζινπίνγκ.
Η Κίνα έχει αναλάβει προγράμματα εξόρυξης μεταλλευμάτων και κατασκεύασε ένα διεθνές αεροδρόμιο και ένα λιμάνι στην Γκουαντάρ, τη νότια παραλιακή πόλη της επαρχίας.
Η καναδική μεταλλευτική ετιαρεία Barrick Gold κατέχει μερίδιο 50% στο ορυχείο Reko Diq στην περιφέρεια Τσαγκάι της επαρχίας, ενώ το υπόλοιπο ανήκει στην κυβέρνηση του Πακιστάν και στην επαρχία. Η Barrick θεωρεί πως το ορυχείο αυτό είναι ένα από τα μεγαλύτερα σε μεγάλο βαθμό ανεκμετάλλευτα κοιτάσματα χαλκού και χρυσού στον κόσμο.
Πηγή: ΑΠΕ – ΜΠΕ